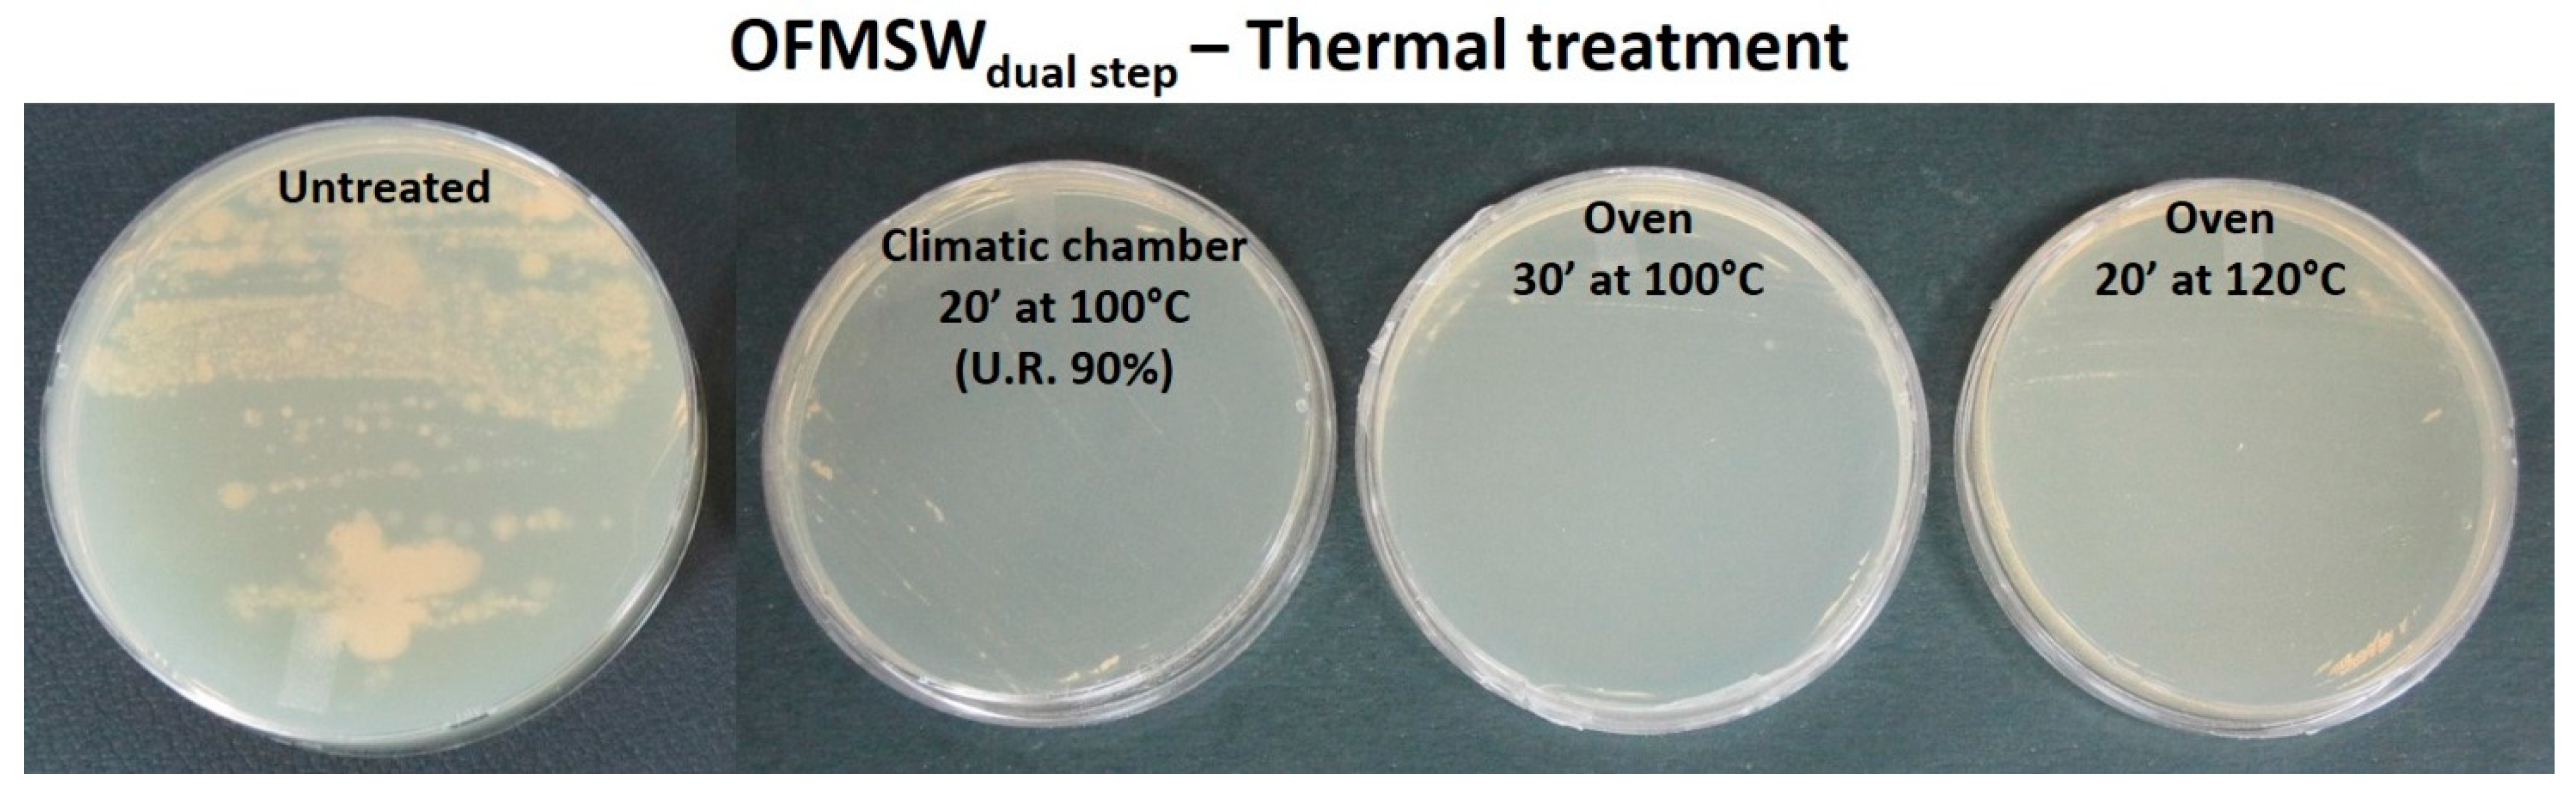
Applsci 09 04516 g004
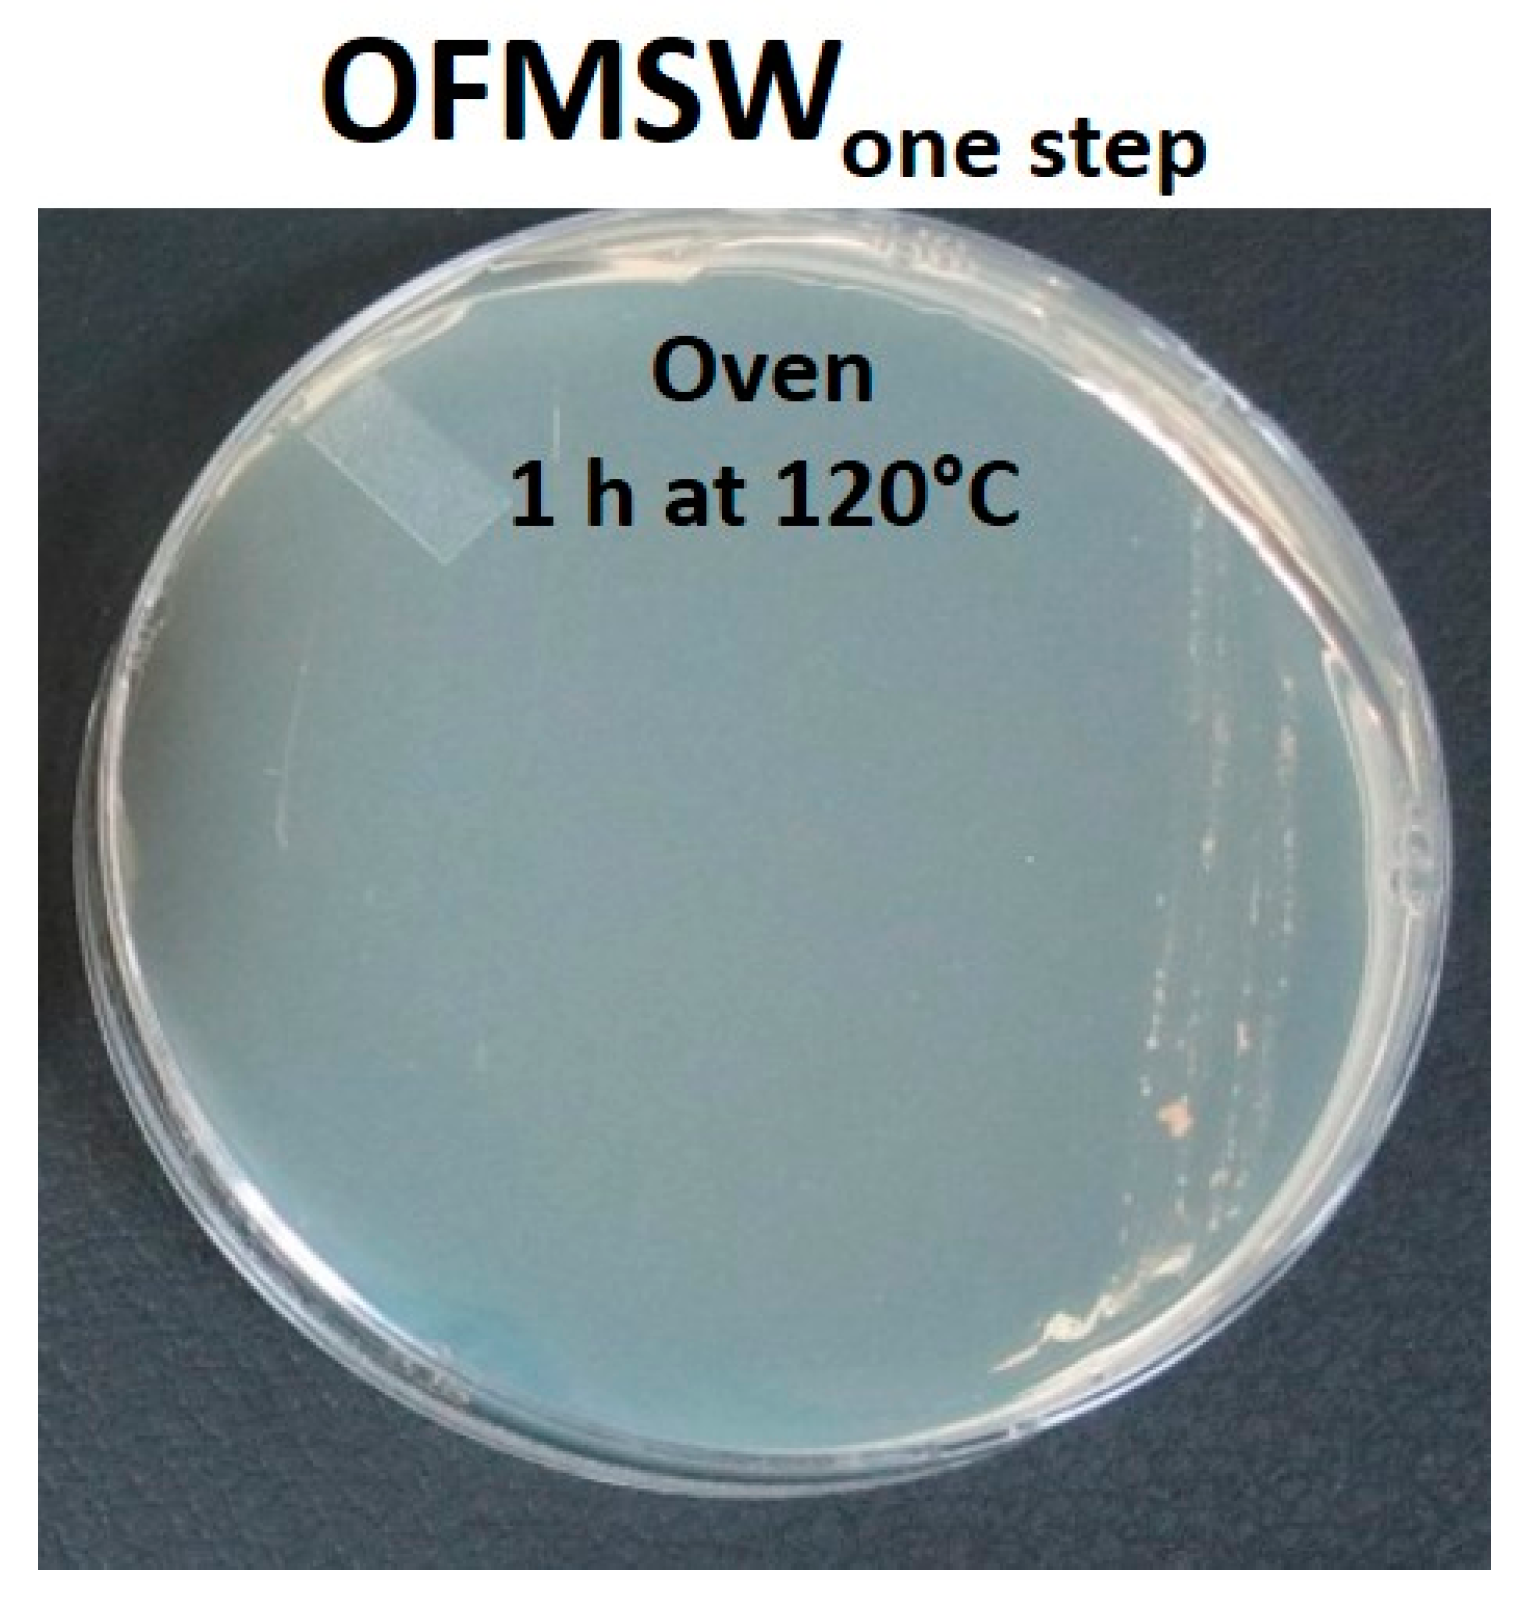
Applsci 09 04516 g005

1. Introduction
One of the major challenges in waste management and disposal are the excessive waste streams deriving from the different sectors of the current linear economic model. Municipal waste accounts for only about 10% of the total waste generated [
1]. Municipal solid waste consists of waste collected by or on behalf of municipal authorities and disposed through the waste management system [
2]. The amount of municipal solid waste, globally collected per year, is approximately 1.3 × 10
12 t and it is expected to rise up to 2.2 × 10
12 t per year by 2025 [
3].
Municipal solid waste contains a significant fraction of paper, food waste, wood and yard trimmings, cotton, glass, metals and leather, as well as derivatives of fossil raw materials such as plastics [
1]. Some 46 wt% of European municipal solid waste is organic waste, below to referred as OFMSW, composed of food waste deriving from homes, restaurants and markets. Specifically, the European Union (EU) produces 8.9×10
7 t of organic municipal solid waste per year and this amount is expected to rise to 1.26×10
8 t by 2020 [
4]. Domestic waste and waste from industrial processing represent the major part in the total amount of municipal solid waste (relatively only the EU produces about 47 × 10
6 t of domestic waste and about 17 × 10
6 t of waste from industrial processing) [
5]. Due to the significant quantities of organic municipal solid waste produced worldwide and the consequent negative environmental impact, local, national and European authorities have undertaken various activities finalized towards the implementation of different management solutions regarding this type of waste. Recently, Cobo et al. [
6] developed a model able to optimize the flows of organic waste and their management by considering the circularity and sustainability criteria. Nevertheless the complexity of the superstructure comprising different management technologies, the same authors declared in their first study that: “the complete circularity of the nutrient flows within any Circular Integrated Waste Management System is infeasible” [
6]. Afterwards, Cobo et al. [
7] improved their model in order to recover nutrients from the municipal organic waste by considering typology, life cycle and costs.
Conventional techniques widely applied for the treatment and management of organic waste in developing countries consist of animal feeding, composting, anaerobic digestion, incineration and disposal in landfills [
8]. Disposal in landfills causes several environmental issues including emissions of greenhouse gas, unpleasant smell production and the formation of leachate. Due to the composition of organic waste and the high water content, incineration is an energy demanding and inefficient process that also entails air pollution [
8]. Composting is a process during which the organic materials are converted into low value-added products [
8]. On the other hand, thermochemical conversion processes (e.g., pyrolysis, gasification, liquefaction) and bio-chemical conversion methods (e.g., anaerobic digestion, fermentation, microbial fuel cell) are more advanced approaches for the treatment and management of organic waste in conjunction with the potential to produce value-added bio-based chemicals, polymers, fuels and energy [
9]. Through the development of proper methods and systemic approaches, different types of biogenic wastes can be converted into diversified types of bio-energy products (e.g., biogas, syngas, methane, hydrogen, electricity), targeting various market outlets under the framework of a circular economy [
2]. Mirabella et al. presented a summary of the different aspects of the valorization of vegetable and fruit wastes for the extraction of bioactive compounds and nutrients [
10]. An innovative approach for the valorization of bakery waste for the production of bio-colorants has been proposed by Haque et al. [
11]. Agro-industrial, dairy and food processing wastes have been recently used for the production of bio-surfactants [
12].
Though the production of biogas is a valid method to recycle organic waste, it cannot be used in some situations where a long disposal period can cause the proliferation of bacterial loads and the production of bad smells, such as for example on cruise ships. As in the past [
13], the problem of biomass storage is still current. The in-depth study of Barhs [
14] on the evolution over the years of biogas exploitation for the production of energy and the insights of Mangold et al. [
15] about the influence of collection date and the ensiling on the yield for the methane production by the
Miscanthus genotypes, prove that an important limit for anaerobic digestion is the storage, so continuous feeding is necessary in biogas plants. The use of organic waste for the realization of bio-products was also recently analyzed. Cerda et al. [
16] discussed solid-state fermentation (SSF). In dry conditions the waste material (solid biomass) can become a substrate for bio-transformations for producing aromas, biosurfactants, biopesticides, bioplastics, organic acids or phenolic compounds. However, an important issue associated with the use of the organic waste is its heterogeneity. The aim of this paper is, hence, the design of an innovative, easy and cheap method for the stabilization (i.e., sterilization) and valorization of the organic fraction of municipal solid waste (here in after OFMSW), by its incorporation in a thermosetting polymeric resin for the production of fully inert panels. This process is extremely robust and reliable, being the quality of the produced panels substantially independent of the nature of OFMSW. The panels produced in this work are odorless and completely sterile, allowing for easy storage. The mechanical properties of the samples produced allow their use for further applications, such as for the replacement of MDF panels, for the production of garden and outdoor furniture items or for thermal-acoustic insulation by providing an added value to the product. Moreover, the developed OFMSW’s transformation process is robust (towards parameters and variables that can influence it), reliable and above all independent of the nature, intrinsically non-homogeneous, of the processed OFMSW for obtaining reproducible technical features of the manufactured products or panels for each considered application. In particular, the main applications identified for the machinery products, in form of bricks or panels, constituted by OFMSW and UF resin are:
- -
Thermal or acoustic insulating panels for building application;
- -
Medium-density fibreboard (MDF)-like panels for building applications;
- -
Garden or outdoor furniture items.
The mechanical tests carried out confirmed that the produced panels are not suitable for the production of structural elements, but they can be used for not structural applications (e.g., as filler of non-structural elements in place of chipboard or blockboard panels) [
17] and for indoor and outdoor furnishings. Specifically, the realized bricks can be used for realizing panels to be covered in order to hide the unavoidable imperfections (e.g., sandwich panels with coverage through wooden sheets); they can’t be used for decorative applications or, in general, in the case of visible uses, because they have residual defects (mm-scale depressions or roughness) arising from the OFMSW transformation process. For instance, these eco-compatible products could be employed as filler for interior doors, filler panels for the interior of non-visible parts of the ships (as an alternative to poplar boards), backrests of sofas or chairs, where no particular mechanical property is required, as instead required for the seat. Finally, the designed prototype machinery could be used, by employing molds with different shapes, to produce the finished products directly, as gardening pots, flowerpots or garden furnishings, with the obvious advantage as no other company would be needed.
The primary step of this work includes the development of efficient method for the bacterial load removal (i.e., stabilization step), by using conventional sterilization methods. Satisfactory evaluation of a new preservation technology depends on reliable estimation of its efficacy against pathogenic and spoilage food-borne microorganisms. Research on alternative technologies was initially focused on process design, product characteristics and kinetics of microbial inactivation. The success of these new technologies, however, depends on progress in understanding microbial physiology and behavior of microbial cells during and after treatment [
18]. Among them, UV and ozone radiation could be considered suitable for our aim to eliminate bacteria from OFMSW.
The second step for the production of panels involved the incorporation of the OFMSW into a thermoset matrix (i.e., sterilization step). The pre-polymerized UF-based commercial resin SADECOL P 100N (Sadepan Chemical Company, Mantova, Italy city, state abbrev if USA, country), employed during the experimental activity for the OFMSW inertization step, is featured by a formaldehyde content less than 1% wt (on average 0.5% wt); it is nowadays widely used around the world by companies for producing wood-based panels and furniture, also derived from recycled wood and, compared to other polymeric matrices, and it has enabled us to overcome several technical issues concerning the present research project thanks to its high solubility in water, rapid curing process times at relatively low temperature and not least, a low cost.
Commercial panels and furniture made by different companies from recycled wood by using the Sadecol be consistent in capitalization P 100N resin have been already classified as low emission E1-class products, due to very low release of free formaldehyde in the air, according to the EN 120 and EN 717 European standards and, consequently, they can be used without generating a free-formaldehyde equilibrium concentration above 0.1 ppm, the upper limit fixed by the World Health Organization for living areas.
Finally, after reporting the results on the optimization of OFMSW’s sterilization, inertization and valorization processes and on the mechanical and chemical properties of the manufactured products, a brief description of the prototype machinery designed for the subsequent engineering of the entire OFMSW transformation process is reported, together with some 3D images showing the functional units of the designed machinery.
2. Materials and Methods
The OFMSW used in this paper is a variegate waste from the restoration sector, consisting mainly of food scraps and food preparation derivatives. The thermosetting resin used in this work for the inertization of OFMSW is a urea formaldehyde (UF) powder polymer, produced by Sadepan Chemical Company as SADECOL P 100N. It is supplied as fine powder/granules with defined grain size and a viscosity of 60 ÷ 130 mPa s at 20 °C. The first proposed OFMSW transformation process is called dual step, since the reduction of the bacterial activity and the setting reaction of the polymeric matrix are performed separately. In this process, the OFMSW is firstly subjected to a grinding process followed by stabilization, which is performed by means of UV/ozone exposure or a thermal treatment. After, the stabilized and finely ground OFMSW and UF powder are mixed in a water slurry, which can be processed by a pressure-free process, as reported in the scheme of
Figure 1.
The water content for each ground OFMSW batch was evaluated by thermogravimetric analysis (TGA); for this purpose, a Netzsch STA 409 simultaneous thermal analyzer (Netzsch, Verona, Italycity, state abbrev if USA, country) was used, heating samples from room temperature to 700 °C with a heating rate of 10 °C/min in N2 atmosphere. Ten replicates were performed in order to measure the water amount in OFMSW.
The stabilization step, i.e., the sterilization of the OFMSW, was performed by means of:
- (a)
UV/ozone treatment. The UV/ozone radiation method was implemented by means of a Hg UV lamp (HG 1000 ULTRA, JELOSIL Srl, Vimodrone MI, Italy company, city, state abbrev if USA, country) with a radiation intensity on the surface of the sample of 9.60 W/mm2, working in air atmosphere. The ground OFMSW samples were exposed to Hg UV lamp irradiation for a time ranging from 1 h to 5 h.
- (b)
Thermal treatment. Three different thermal treatments were performed by exploiting humid or dry conditions.
OFMSW was exposed to T = 100 °C for 20 min (with relative humidity of 90%) in a climatic chamber (Binder, Guangdong, China city, state abbrev if USA, country).
OFMSW was exposed at T = 100 °C for 30 min (dry environment) in an oven (Lenton, Hope Valley, UK city, state abbrev if USA, country).
OFMSW was exposed at T = 120 °C for 20 min (dry environment) in an oven (Lenton).
The effectiveness of each sterilization method was evaluated by means of in-vitro microbiological tests by spreading OFMSW treated samples on agar plates. Nutrient agar (0.3% wt/v beef extract, 0.5% wt/v peptone, 1.5% wt/v agar) was used as a non-selective medium supporting growth of a wide range of organisms. The agar medium was pre-sterilized in an autoclave at 121 °C for 30 min and dispensed into Petri dishes. The agar plates were allowed to solidify for about 30 min in a biosafety cabinet. Each sample was picked up with a sterile inoculating loop and spread over the surface of the medium. Then, the plates were incubated at 37 °C overnight and, after incubation, they were visually inspected for macroscopic growth of bacterial colonies.
In the inertization step, stabilized OFMSW was mixed with water and UF-based SADECOL P 100N resin, in order to produce a slurry, which was then cured at T = 120 °C for 1 h. After curing and water evaporation, a UF/ OFMSW composite was obtained, which was characterized by means of thermal, physical and mechanical tests. For comparison purpose, a formulation without OFMSW was also realized. The compositions of the two mixtures produced by the two step process (P100N UF, OFMSW_P100N UF) are reported in
Table 1. As preliminary approach, the ratio 70/30 between the solid phase (which includes the matrix and the dried OFMSW) and water was chosen. Tests on different compositions are shown in the second part of the present paper [
17].
A further simplified transformation process was also employed in order to reduce time duration and costs. Compared to the dual-step process, the one-step process allows performing the reduction of the bacterial activity simultaneously with the curing of the thermosetting matrix. Also, the addition of the slurry without any preliminary treatment avoids further addition of water, exploiting the water contained in the OFMSW.
To this aim, the blend of wet OFMSW and UF was heated at a temperature of 120 °C and kept at the same temperature for 1 h for allowing in the same time the reduction of the bacterial charge and the curing of the UF-based matrix. All the process is summarized in the simplified scheme of
Figure 2.
In the case of one step method, different additives, wastes (i.e., coffee powder) or recycling materials (i.e., sawdust), were also added to the OFMSW/P100N UF composites in order to evaluate their effect on physical-mechanical properties of the one step processed samples. The compositions of the one step cured samples, with and without the wastes additives are reported in
Table 2.
Rheological analyses were carried out by using a Rheometrics Ares rheometer (TA, New Castle, DE company, city, state abbrev if USA, country). Dynamic tests were performed from room temperature to 140 °C at a heating rate of 3 °C/min. In order to determine the time necessary to complete the curing reaction, a further isothermal rheological analysis at 120 °C was performed; a double plate geometry was used, setting a gap of 0.3 mm, constant oscillatory amplitude (1%) and frequency equal to 1 Hz.
All the mixtures were poured in silicon molds and put in a static oven at 120 °C for the time necessary to complete the cure reaction (i.e., 1 h).
Flexural tests were performed on six samples (100 mm × 10 mm × 3 mm) obtained after inertisation, using a Lloyd LR5K dynamometer (Lloyd Instruments, Roma, Italy city, state abbrev if USA, country) and a crosshead speed of 1.5 mm/min.
An AXIO-LINKAM optical microscope (Zeiss, Milano. Italycity, state abbrev if USA, country) was used for the morphological characterization of the materials. The size of the pores was obtained as an average of 50 measurements.
Analysis of variance (ANOVA) was used to highlight the statistical significance of different parameters, as the different processes or the different additives on the mechanic properties. To this purpose, the F value, which is defined as the ratio of the variation between sample means to the variation within the samples, was calculated from the measured data. Then, being “a” the number of levels of the variance factor, and “n” the number of tests for each level, the critical F value, FCV(a-1, a(n-1),α), can be estimated. FCV represents the value of F distribution with degrees of freedom (a-1) and a(n-1), which, at a confidence level, α, corresponds to the null hypothesis (equivalence of the means). F<FCV indicates that the population means are equivalent, while F>FCV indicates that the population means are significantly different [
19]. Another quantitative measure for reporting the result of a test of hypothesis is the
p-value. The
p-value is the probability of the test statistic to be at least as extreme as the one observed, given that the null hypothesis is true. A small
p-value is an indication that the null hypothesis is false. It is good practice to decide in advance of the test how small a
p-value is required to reject the test, that is, to choose a significance level, α, for test. For example, it can be decided to reject the null hypothesis if the test statistic exceeds the critical value (for α = 0.05) or, analogously, to reject the null hypothesis if the
p-value is smaller than 0.05.
4. Conclusions
The carried out research activity, supported by European Union’s Horizon 2020 research and innovation program, aimed to realize an automated machinery, with different sizes depending on place where it has to be installed (domestic—residential use, restaurants as well as isolated mountain communities where the OFMSW’s daily collection can be difficult), for targeted treatment of the conferred OFMSW by means of its transformation in an inertised, valorised and identifiable (namely traceable) products that can then be used for different purposes. The developed process will lead to several advantages compared to what generally happens today for OFMSW’s disposal and treatment:
The inertization and stabilisation allow a harmless and advantageous lasting storability of the treated- OFMSW;
The harmlessness over time guarantees the eco-sustainability regardless subsequent path of the OFMSW-derived panels-bricks produced by the machinery;
The waste’s valorisation allows an extension of the possibilities of its reuse;
The Radio Frequency identification (RFID) by using suitable wide-band low-cost passive UHF tags allows the traceability of the machinery’s products ensuring targeted and optimal management of the re-use or storage of the valorized products;
The codified identification allows the computerized management ensuring advantages for the public entities and citizens.
Specifically, in this paper two original processes (called dual and one step) for transforming the organic waste (OFMSW) into an inert, odorless and sanitized material were proposed. To this aim, new green composites were realized through the incorporation of the OFMSW finely ground in a thermosetting urea-formaldehyde (UF) based resin. OFMSW /UF composites produced with the two-step method were firstly analysed by dynamic rheological analysis, in order to select the optimal curing conditions, even in presence of OFMSW. The mechanical results obtained on the cured samples produced with both dual and one step processes, highlight that the OFMSW /UF composites are characterized by higher mechanical properties compared to the neat resin. This last result was attributed to a decreased water evaporation rate, due to the presence of OFMSW and, in turn, to a less porous composites structure, as confirmed by optical microscopy analysis. Both methods proposed in this paper could be considered suitable for the production for example of Medium-density fibreboard (MDF)-like panels for building applications or thermal and acoustic insulating waste-based bricks to be used as filler in non-structural applications, as in detail previously discussed. A rough cost estimation of the developed procedure is presented in second part of the present paper, proving the potential cost saving compared to the neat matrix [
17]. Such a cost estimation must account for the fact that, compared to the standard processing of the UF resin, an additional cost is given by the sterilization, but the production of the blend, allows to reduce the cost due to the reduced UF consumption. In addition, the detailed results on the mechanical and thermal specifications obtained by the OFMSW-derived bricks or panels, made using the prototype machinery described above at the design stage, will be illustrated in another scientific work being prepared but here we can anti-cipate that the obtained values will allow their use in the proposed applications based on the existing standards on the technical specifications and low emission level of free formaldehyde in the air.
Finally, an important advantage of this project, in terms of the environmental impact, lies in the reduction of CO2 emissions, since the organic waste, if not properly and quickly treated, becomes a source of carbon dioxide emissions.